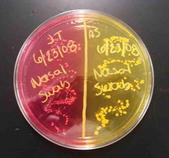

| ||||
Mannitol Salt Agar (MSA)
Bacterial Growth Media
Differential + Selective Medium to Grow & ID Staphylococcus Bacteria
When bacterial cultures are grown in a laboratory environment, they are essentially captives, part of a microbial zoo dependent on people to provide the proper environment for their survival and growth. A nutrient-rich media is required to grow bacteria in the lab.
Article Summary: Mannitol Salt Agar is a special bacterial growth medium that is selective for halophiles and can differentiate pathogenic and nonpathogenic Staphylococcus.
Mannitol Salts Agar (MSA) Specialized Media
Page last updated: 4/2016
Two plates of Mannitol Salt agar. Left plate growing
Staphylococcus aureus, a pathogenic mannitol fermenter. Right plate growing non-mannitol fermenter S. epidermidis.
Click here for more images of Mannitol Salt Agar.
You have free access to a large collection of materials used in a college-level introductory microbiology course. The Virtual Microbiology Classroom provides a wide range of free educational resources including PowerPoint Lectures, Study Guides, Review Questions and Practice Test Questions.
SCIENCE PHOTOS
 | ||||||
SPO VIRTUAL CLASSROOMS
What is Media?
A growth medium (plural: media) is a mixture of nutrients, moisture and other chemicals thatbacteria need for growth. Media aren’t used to directly examine individual bacteria, but rather to grow colonies (millions of bacteria having arisen through the binary fission of a single progenitor).
See Page 2 for information on the differential reaction of Mannitol Salt Agar, more photos and a video!
Using Media to Identify Bacteria
Like the differential staining of bacteria, special types of media can be used to provide clues about a microbe’s identity. There are many types of solid media that are specific about what they grow, or that provide information about the type of microbes present.
Some media are solid, such as Jell-O-like agar. When hot, agar is liquid that can be poured into the bottom half of a Petri dish; once cooled, it solidifies, providing a surface for bacterial growth. There are also liquid media broth that allows for bacterial growth suspended in test tubes.
Hot Tryptic Soy Agar Being Aseptically Transferred to Sterile Petri Dishes
Selective and Differential Media
If a bacterial growth medium is selective, that means that it grows only certain types of microbes while inhibiting the growth of other types of microbes. A growth medium is considered differential if, when specific microbes are present, the medium, or bacterial colonies themselves, exhibit a color change that provides information about their identity.
Mannitol Salt Is Selective
Mannitol Salt is a selective bacterial growth medium because it has a very high concentration of NaCl (7.5%). Most bacteria cannot survive in this highly saline, hypertonic environment. But the genus Staphylococcus has a protective slime layerthat protects it in a harsh, salty environment. So Staph grow well in this media.
Because of their slime layer, and ability to form biofilms, S. epi normal flora can become problematic (opportunistic) when it begins to grow in layers on plastic internal medical devices. So the slime layer is a major virulence factor for Staphylococcus.
Differential and selective media can exclude certain types of bacteria and even test for certain bacterial metabolic capabilities that are the result of a species' unique genetic makeup. MacConkey’s
(MAC), Blood agar (BAP), and Mannitol Salt (MSA) are three examples of these specialized types of media.
Sterile specialized bacterial growth media. From top clockwise: MaCConkey's, Blood Agar & Mannitol Salt.